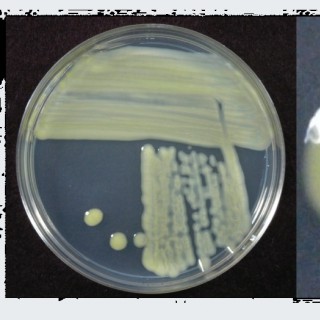

Podcasts about Xanthomonas
- 12PODCASTS
- 13EPISODES
- 37mAVG DURATION
- 1MONTHLY NEW EPISODE
- Feb 26, 2024LATEST
POPULARITY
Latest news about Xanthomonas
- CRISPRi in Xanthomonas demonstrates functional convergence of Transcription Activator‐Like effectors in two divergent pathogens Wiley: New Phytologist: Table of Contents - Feb 11, 2023
Latest podcast episodes about Xanthomonas
#EP226 MAP GENES DE RESISTÊNCIA CONTRA DOENÇAS EM PLANTAS COM BEATRIZ FRANCESCHI - UNIVERSIDADE DA FLÓRIDA
#EP226 MAP GENES DE RESISTÊNCIA CONTRA DOENÇAS EM PLANTAS COM BEATRIZ FRANCESCHETI - UNIVERSIDADE DA FLÓRIDANo Episódio de hoje, eu Prof. Rogério Coimbra converso com a Beatriz Franceschi. Engenheira Agrônoma pala Universidade Estadual Paulista - UNESP (FCA) de Botucatu. Atualmente ela esta realizando o Doutorado na Universidade da Flórida. Desenvolvendo pesquisado com com os mecanismos pelos quais o gene Xa21 do arroz confere resistência contra a doença bacteriana e as abordagens para engenharia de amplo espectro e resistência durável nas culturas, ela vai nos detalhar tanto a vida em uma universidade dos EUA e os detalhes dos seus estudos.Lembre que você sempre pode interagir com o MAP nas redes sociais e também deixar seu comentário, avaliação ou recado aqui nos comentários. Sua opinião é muito importante e nos ajuda a melhorar cada vez mais nosso Podcast. Deixe sua sugestão de tema e convidados para que possamos continuar produzindo conteúdos de qualidade para você. Avalie o Mundo Agro Podcast no App da Apple Podcast, isso nos ajuda a crescer e melhorar. Instagram: @biafranceschiLinkedIn: https://www.linkedin.com/in/beatriz-de-toledo-franceschiParceiro Institucional: MOMESSO: https://momesso.ind.br/Patrocinadores: Momesso: https://momesso.ind.br/Agro-Sol Sementes: https://agrosolsementes.com.br/SIGA O MUNDO AGRO PODCAST NAS REDES SOCIAL:Instagram: https://www.instagram.com/mundoagropodcast/YouTube: https://www.youtube.com/mundoagropodcastE-MAIL E MÍDIA KIT:producao.mundoagropodcast@gmail.comLEMBRE-SE DE COMPARTILHAR ESSE PODCAST, ISSO FORTALECE O NOSSO AGRONEGÓCIO. Um Forte Abraço e nos vemos por aí...#mundoagropodcast
#EP226 MAP GENES DE RESISTÊNCIA CONTRA DOENÇAS EM PLANTAS COM BEATRIZ FRANCESCHI - UNIVERSIDADE DA FLÓRIDA
#EP226 MAP GENES DE RESISTÊNCIA CONTRA DOENÇAS EM PLANTAS COM BEATRIZ FRANCESCHETI - UNIVERSIDADE DA FLÓRIDANo Episódio de hoje, eu Prof. Rogério Coimbra converso com a Beatriz Franceschi. Engenheira Agrônoma pala Universidade Estadual Paulista - UNESP (FCA) de Botucatu. Atualmente ela esta realizando o Doutorado na Universidade da Flórida. Desenvolvendo pesquisado com com os mecanismos pelos quais o gene Xa21 do arroz confere resistência contra a doença bacteriana e as abordagens para engenharia de amplo espectro e resistência durável nas culturas, ela vai nos detalhar tanto a vida em uma universidade dos EUA e os detalhes dos seus estudos.Lembre que você sempre pode interagir com o MAP nas redes sociais e também deixar seu comentário, avaliação ou recado aqui nos comentários. Sua opinião é muito importante e nos ajuda a melhorar cada vez mais nosso Podcast. Deixe sua sugestão de tema e convidados para que possamos continuar produzindo conteúdos de qualidade para você. Avalie o Mundo Agro Podcast no App da Apple Podcast, isso nos ajuda a crescer e melhorar. Instagram: @biafranceschiLinkedIn: https://www.linkedin.com/in/beatriz-de-toledo-franceschiParceiro Institucional: MOMESSO: https://momesso.ind.br/Patrocinadores: Momesso: https://momesso.ind.br/Agro-Sol Sementes: https://agrosolsementes.com.br/SIGA O MUNDO AGRO PODCAST NAS REDES SOCIAL:Instagram: https://www.instagram.com/mundoagropodcast/YouTube: https://www.youtube.com/mundoagropodcastE-MAIL E MÍDIA KIT:producao.mundoagropodcast@gmail.comLEMBRE-SE DE COMPARTILHAR ESSE PODCAST, ISSO FORTALECE O NOSSO AGRONEGÓCIO. Um Forte Abraço e nos vemos por aí...#mundoagropodcastSee omnystudio.com/listener for privacy information.
Greenhouse & Nursery Diseases: Focus on Summer with Dr. Ann Chase & Dr. Aaron Palmateer
In this episode of Tech On Demand brought to you by GrowerTalks, host Bill Calkins is joined for the second time by Dr. Ann Chase, owner of Chase Agricultural Consulting, and Dr. Aaron Palmateer, technical development lead for the ornamental business at SePRO. Both are expert-level plant disease gurus with decades of combined work in the field. Last time we talked with Ann and Aaron, the discussion centered on what to expect—from a disease perspective—in spring production. If you didn't listen to that one, jump back in the archives and check out Episode 33. This time, we're moving on to summer, but first, the guests reflect back on spring for a bit before jumping right into warm-season diseases like Phytophthora, Rhizoctonia, soft rots like Erwinia, Southern Blight, Xanthomonas and plenty more. They discuss what they've seen in greenhouses and nurseries already this summer and what they expect to see soon—more than 25 diseases they've seen first-hand. One of the most interesting parts of this cast is a rundown of common diseases and the temperature ranges that bring them on. The episode continues with thoughts on why producing crops (like vinca, poinsettias and fall pansies) out-of-season often requires the most vigilance and hardest work by production teams before concluding with an in-depth look at the most cutting-edge control strategies for summer diseases. Resources: Dr. Ann Chase: archase@chaseresearch.net Dr. Aaron Palmateer: aaronp@sepro.com Chase Horticultural Research: www.chaseagri.com SePRO: https://www.sepro.com/Hort BE SURE TO SUBSCRIBE TO THE TECH ON DEMAND PODCAST ON ANY MAJOR PODCAST APP SO YOU NEVER MISS AN EPISODE!
185 Enfermedades, mancha bacteriana del chile y tomate
La mancha bacteriana (Xanthomonas campestris) es una bacteria que ataca al chile y al tomate, aunque también puede atacar al tabaco. El problema que genera es que afecta la calidad de los frutos al punto de que ya no pueden ser comercializables, además de que su control químico se vuelve costoso. https://podcastagricultura.com/episodio-185/
Transcriptome analysis of resistant and susceptible pepper (Capsicum annuum L.) in response to Xanthomonas campestris pv. Vesicatoria
Link to bioRxiv paper: http://biorxiv.org/cgi/content/short/2020.09.24.311274v1?rss=1 Authors: Gao, S., Wang, F., Niran, J., Li, N., Yin, Y., Yu, C., Jiao, C., Yao, M. Abstract: Bacterial spot (BS) disease of pepper, incited by Xanthomonas campestris pv. Vesicatoria ( Xcv ), is one of the most serious diseases. For a comparative analysis of defense response to Xcv infection, we performed a transcriptome analysis of BS -susceptible cultivar ECW and -resistant cultivar VI037601 using the HiSeq TM 2500 sequencing platform. Approximately 140.15 G clean data were generated from eighteen libraries. From the libraries generated, we identified 52,041 genes including 35,336 reference genes, 16,705 novel transcripts, and 4,794 differentially expressed genes (DEGs). There were 1,291, 2,956, 1,795 and 2,448 DEGs in ECW-24h-vs-ECW-0h, ECW-48h-vs-ECW-0h, VI037601-24h-vs-VI037601-0h and VI037601-48h-vs-VI037601-0h groups, respectively. Interestingly, DEGs involved in disease response in the resistant variety were induced at an earlier stage and at higher levels compared with the susceptible variety. Key enriched categories included amino sugar and nucleotide sugar metabolism, sesquiterpenoid and triterpenoid biosynthesis and MAPK signaling pathway. Moreover, 273 DEGs only differentially expressed in VI037601 and 436 overlapping DEGs in ECW and VI037601 post Xcv inoculation, including NBS-LRR genes, oxidoreductase gene, WRKY and NAC transcription factors were identified, which were mainly involved in metabolic process, response to stimulus and biological regulation pathways. Quantitative RT-PCR of sixteen selected DEGs further validated the RNA-seq differential gene expression analysis. Our results will provide a valuable resource for understanding the molecular mechanisms of pepper resistance to Xcv infection and improving pepper resistance cultivars against Xcv . Copy rights belong to original authors. Visit the link for more info
John Kempf and Ed Curry take the stage in Louisville, KY at the ACRES Conference 2018 — a hotbed for regenerative agriculture practitioners for the last 30 years — to record the Regenerative Agriculture Podcast’s first ever LIVE show. The Acres Conference isn’t just another trade show or conference; this is a gathering of passionate and purposeful people working to share information and tools, and challenge the status quo in agriculture for the greater good. This is why we chose Acres 2018 for our first ever Podcast LIVE and why John and Ed make such a great pair to co-create this inaugural episode at this event. Ed is an old-school breeder and grower with a new-school mentality. More than 90% of the green chiles grown in the US and Mexico are from Ed’s breeding program. He is now the only breeder of his kind in the world. Even if you don’t grow chiles, you can certainly learn something from this discussion. The show covers important topics such as: The art of visual phenotyping Soil health’s impact on genetics Increase in yield by maximizing genetic potential over time Visually measuring the yield and quality of a chile crop within 30 days of planting The relationship between early vigor and crop yield How Ed’s management practices have brought steady decreases in Phytophthora and Xanthomonas bacterial spot Ed’s prediction for the coming capsaicin revolution and its many positive benefits One of the most powerful things Ed says is, “The soul of farming is the soil.” We agree. The finale of our first season, episode #30, represents a huge milestone and our first ever Podcast LIVE. A huge THANK YOU is in order to all our amazing listeners around the world in the regenerative ag community who have supported this show and helped to make it such a success. We hope you have a lovely holiday and we look forward to sharing the second season of the Regenerative Agriculture Podcast with you in the new year. Thank you, The Regenerative Agriculture Podcast Team Support For This Show & Helping You Grow This show is brought to you by AEA, leaders in regenerative agriculture since 2006. If you are a large-scale grower looking to increase crop revenue and quality, email hello@advancingecoag.com or call 800-495-6603 extension 344 to be connected with a dedicated AEA crop consultant. Feedback & Booking Please send your feedback, requests for topics or guests, or booking request have a Podcast episode recorded LIVE at your event -- to production@regenerativeagriculturepodcast.com. You can email John directly at John@regenerativeagriculturepodcast.com. Sign Up For Special Updates To be alerted via email when new episodes are released, and get special updates about John speaking, teaching, and podcast LIVE recordings, be sure to sign up for our email list. Credits This episode was Directed by Geoffrey Shively, Edited by Nathan Harman, Produced by Nathan Harman, Robin Kitowski, Jenna Sodano, and Anna Kempf.
In this week's AgPhD Episode, you will learn about seed traits, and how they are beneficial in today's world. Then, the Hefty brothers talk about which pre-emerge wheat products you should use. They discuss a new corn disease caused by the bacterium Xanthomonas, and then the Weed of the Week is Yellow Foxtail. Finally, Darren talks about incorporating your soybean pre-emerge herbicides in his Iron Talk segment.
In this week's AgPhD Episode, you will learn about seed traits, and how they are beneficial in today's world. Then, the Hefty brothers talk about which pre-emerge wheat products you should use. They discuss a new corn disease caused by the bacterium Xanthomonas, and then the Weed of the Week is Yellow Foxtail. Finally, Darren talks about incorporating your soybean pre-emerge herbicides in his Iron Talk segment.
Sequence diversity and functional conformity
Fakultät für Biologie - Digitale Hochschulschriften der LMU - Teil 06/06
At least four phylogenetically distinct groups of bacteria encode repeat proteins with the common ability to bind specific DNA sequences with a unique but conserved code. Each repeat binds a single DNA base, and specificity is determined by the amino acid residue at position 13 of each repeat. Repeats are typically 33-35 amino acids long. Comparing repeat sequences across all groups reveals that only three positions are hyper-conserved. Repeats are in most cases functionally compatible such that they can be assembled together into a single chimeric array. This functional conformity and inter-compatibility is a result of structural conservation. Repeat arrays of these proteins have been demonstrated or predicted to form almost identical tertiary structures: a right-handed super helix that wraps around the DNA double strand with the base specifying residue of each repeat positioned in the major groove next to its cognate target base. The mechanism of DNA binding is conserved. The first discovered group, providing the name for the rest, are the Transcription Activator Like Effectors (TALEs) of plant-pathogenic Xanthomonas bacteria. The eukaryotic transactivation domain, which lends this group their name, allows them to activate specifically targeted host genes for the benefit of the bacterial invader. The other groups, discovered after the TALEs, are the RipTALs of Ralstonia solanacearum, the Bats of Burkholderia rhizoxinica, and MOrTL1 and MOrTL2 of unknown marine bacteria. Together they are designated TALE-likes. Each designation contains some allusion to the TALEs. The term RipTAL stands for Ralstonia injected proteins TALE-like, the Bats are Burkholderia TALE likes, and the MOrTLs Marine Organism TALE-likes. This unity of terminology belies disunity in the lifestyles of these different bacteria, and the biological roles fulfilled by these proteins. The TALEs have already been researched extensively. The code that describes the relationship between the base specifying residues and their cognate bases is often referred to as the TALE code. This code was deciphered by two groups independently and published in 2009, a year before I began my doctoral work. Since then research into TALEs has not slowed and a great deal has been learnt both about the native biology and biotechnological uses of TALEs. My work has been focused on the other TALE-like groups, none of which had been previously characterized in terms of DNA recognition properties, before I began my work. RipTALs are effector proteins delivered during bacterial wilt disease caused by R. solanacearum strains. This devastating disease affects numerous crop species worldwide. Characterizing the molecular properties of the RipTALs provides a first step towards uncovering their role in the disease. The Bats and MOrTLs are primarily of interest as comparison groups to the TALEs and RipTALs and as sources of sequence diversity for future efforts into TALE repeat engineering. In the introduction of this dissertation, which explores TALE biology, a particular focus will be placed on the DNA binding properties of TALEs and how this can be put to use in TALE technology. After this the RipTALs, Bats and MOrTLs are each introduced, explaining what is known about their provenance and sequence features. The aims of my doctoral work are then listed and expounded in turn. The proximal goal of my doctoral work was to carry out a comparative molecular characterization of each group of non-TALE TALE-likes. In doing so we hoped to gain insights into the principles of TALE-like DNA-binding properties, evolutionary history of the different groups and their potential uses in biotechnology. In the case of the RipTALs this work should begin to unravel the role these proteins play in bacterial wilt disease, as a means to fight this devastating pathogen. The articles I have worked on covering the molecular characterizations of RipTALs, Bats and MOrTLs are then presented in turn. Working together with others I was able to show that repeats from each group of TALE-likes mediate sequence specific DNA binding, revealing a conserved code in each case. This code links position 13 of any TALE-like repeat to a specific DNA base preference in a reliable fashion. I will argue that the TALE-likes represent a fascinating case of conserved structure and function in a diverse sequence space. In addition the TALEs and RipTALs may simply represent one face of the TALE-likes, a protein family mediating as yet unknown biological roles as bacterial DNA binding proteins.
RNA-Seq-basierte Isolierung des Resistenzgens Bs4C aus Paprika
Fakultät für Biologie - Digitale Hochschulschriften der LMU - Teil 05/06
Das Paprika Resistenzgen Bs4C aus Capsicum pubescens vermittelt Resistenz gegenüber Xanthomonas campestris pv. vesicatoria (Xcv)-Stämmen, die den (transcription activator-like) TAL-Effektor AvrBs4 exprimieren. Vorangegangene Arbeiten ließen vermuten, dass AvrBs4 die Expression von Bs4C transkriptionell induziert. In einem “proof of principle”-Experiment, wurde Bs4C unter Verwendung eines RNA-Seq-basierten Ansatzes isoliert. Unter 68 differentiell AvrBs4-induzierten Paprikagenen war jedoch nur eines, das ausschließlich in der resistenten und nicht in der suszeptiblen Akzession induziert war und für das kein Transkript in Abwesenheit von AvrBs4 in der resistenten Akzession nachgewiesen wurde. Kopplungs- und Komplementationsanalysen bestätigten dieses Kandidatengen als das gesuchte Resistenzgen Bs4C. Im Bs4C-Promoter konnte ein Effektorbindeelement (EBE) für AvrBs4 identifiziert werden, das notwendig und ausreichend für die AvrBs4-Bindung an und transkriptionelle Aktivierung von Bs4C ist. Bindungsstudien ließen erkennen, dass zwei Nukleotidpolymorphismen in der korrespondierenden Region der suszeptiblen Akzession eine stark reduzierte Affinität (10fach) gegenüber AvrBs4 bedingen. Außerdem zeigten GUS-Studien, dass der Promoter des suszeptiblen Allels nicht durch AvrBs4 induzierbar ist. Folglich bestimmt ein Substitutionspolymorphismus von zwei Basenpaaren in den Promotoren des resistenten und suszeptiblen Bs4C-Allels über Resistenz oder Suszeptibilität gegenüber AvrBs4-exprimierenden Xanthomonaden. Bs4C kodiert für ein 164-AS großes Protein, das keine Homologie zu Proteinen mit bekannter Funktion aufweist. In silico Proteinstrukturanalysen sagen vier Transmembranhelices in Bs4C vorher und demzufolge stellt es einen neuen Typ von Exekutorproteinen dar, welcher Resistenz gegen TALE-exprimierende Xanthomonas-Stämme vermittelt. Zudem konnten Sequenzanalysen mindestens ein Homolog in C. pubescens und mindestens sieben Homologe in C. annuum identifizieren. Interessanterweise kodieren die meisten von ihnen aufgrund von Nukleotidaustauschen, Leserahmenverschiebungen und Insertions/Deletionspolymorphismen nicht für Volllängen Bs4C-ähnliche Proteine. Folglich könnten diese homologen Sequenzen duplizierte Gene repräsentieren, die nicht mehr funktional sind.
C. He - Cyclic di-GMP receptor-mediated regulation of bacterial virulence in Xanthomonas oryzae pv. Oryzae
Chenyang He, State Key Laboratory for Biology of Plant Diseases and Insect Pests, Institute of Plant Protection, Chinese Academy of Agricultural Sciences, Beijing, CHINA speaks on "Cyclic di-GMP receptor-mediated regulation of bacterial virulence in Xanthomonas oryzae pv. oryzae " This seminar has been recorded by ICGEB Trieste
Charakterisierung der molekularen Wirkungen des Y. enterocolitica Effektorproteins YopP auf die Wirtszelle
Fakultät für Biologie - Digitale Hochschulschriften der LMU - Teil 01/06
Yersinien sind auf Grund ihres spezifischen Typ III-Proteinsekretionssystems (TTSS) in der Lage, nach Anlagerung an Zellen bakterielle Virulenzproteine in das Innere der Wirtszelle zu translozieren. Dies führt zu einer Zellparalyse und bei Makrophagen zum Zelltod. Eines der translozierten Virulenzproteine ist YopP/J, das die Signalwege der mitogenaktivierten Proteinkinasen (MAPK) sowie des Transkriptionsfaktors NF-kB in der Wirtszelle inhibiert. Es wird angenommen, dass YopP/J zur Familie der Cystein-Proteasen zählt. Es zeigt Homologien zu AvrRXV/AvrBst von Xanthomonas campestris, welches eine dem apoptotischen Zelltod vergleichbare sogenannte „Hypersensitive Reaktion (HR)“ bei Pflanzen auslösen kann. Die Bakterien der enteropathogenen Spezies Yersinia enterocolitica, welche nach oraler Aufnahme im terminalen Ileum durch M-Zellen in die Lymphfollikel der Peyerschen Plagues wandern, werden anhand ihrer Oberflächen-(O)- und Geißel-(H)-Antigene in verschiedene Serotypen unterteilt. Unsere Studien haben gezeigt, dass sich einzelne Y. enterocolitica-Serotypen in der Apoptoseinduktion bei Makrophagen unterscheiden. In der vorliegenden Arbeit wurde den Mechanismen der Apoptoseinduktion durch die verschiedenen Y. enterocolitica-Serotypen nachgegangen. Zunächst konnte YopP für die unterschiedlichen Apoptose-Effekte verantwortlich gemacht werden. Durch DNA-Austausch und der anschließenden Modifikation einzelner Aminosäuren zwischen YopP von Y. enterocolitica-Serotyp O8 und Y. enterocolitica-Serotyp O9 konnte Arginin (R) an Position 143 als essentielle AS der Effektordomäne von YopPO8 definiert werden. YopP von Y. enterocolitica-Serotyp O9 und Y. enterocolitica-Serotyp O3 besitzt an dieser AS-Position Serin (S). YopPO8 vermittelt deutlich stärker Apoptose als YopPO9 und YopPO3. Der erhöhten Apoptoseinduktion durch YopPO8 geht eine effiziente Unterdrückung der NF-kB-Aktivierung vorraus. Die Inhibition des antiapoptotischen NF-kB-Signalwegs durch YopP scheint Voraussetzung für die Apoptoseinduktion durch Yersinia zu sein. Des weiteren wurde in dieser Arbeit mit Hilfe des Hefe-2-Hybrid-Systems nach neuen unbekannten intrazellulären YopP-Interaktionspartner gesucht. Aus einer Maus-Milz-cDNA-Genbank konnten 22 potentielle YopP-Interaktionspartner isoliert werden. In in vitro-Bindungsstudien konnte bis zum jetzigen Zeitpunkt eine Interaktion von YopP mit vier Proteinen (PP2Ac, FWD2, eEf1bb, Smad1) bestätigt werden. Weiterführende Bindungs- und Funktionsanalysen werden noch durchgeführt. Die möglichen Auswirkungen dieser Interaktionen werden diskutiert. Die durchgeführten Studien erbrachten zudem Hinweise auf eine Modifikation von YopP in der Wirtszelle. Darüberhinaus konnte mit Hilfe des Hefe-2-Hybrid-Systems der Interaktionsbereich von YopP mit seinem Zielprotein IKKb eingeschränkt werden. Die durchgeführten Bindungsanalysen mit IKKb-Deletionsmutationen weisen auf eine Bindung von YopP an den IKKb-N-Terminus hin. Das Ergebniss wurde durch in vitro-Bindungsstudien bestätigt. Unter anderem scheint Alanin an IKKb-Position 120 die Interaktion mit YopP zu bestimmen. So konnten im Rahmen dieser Doktorarbeit unterschiedliche Aspekte der Wechselwirkung von Y. enterocolitica YopP mit der Wirtszelle und Wirtszellproteinen analysiert werden. Diese Studien tragen zum besseren Verständnis der Immunmodulation durch pathogene Bakterien bei.
Immunmodulatorische Funktion der Surfactant-assoziierten Proteine A und D im Rahmen der lokalen Immunabwehr in der Lunge
Medizinische Fakultät - Digitale Hochschulschriften der LMU - Teil 02/19
Die hydrophilen pulmonalen Surfactantproteine A und D (SP-A, SP-D) gehören zur Gruppe der C-Typ Lektine und spielen bei der angeborenen, primären Immunantwort der Lunge eine Rolle. In mehreren Studien wurde gezeigt, dass SP-A und SP-D mit einer Reihe von Mikroorganismen und pulmonalen Entzündungszellen interagieren. In der vorliegenden Arbeit wurde die Funktion von SP-A und SP-D bei der Immunabwehr Mukoviszidose-assoziierter Keime wie Pseudomonas aeruginosa, Xanthomonas maltophilia, Burgholderia cepacia und Staphylococcus aureus untersucht. Hierzu wurden zunächst insgesamt 57 klinische Isolate der Bakterien, darunter 35 P. aeruginosa Stämme, durch Sero- beziehungsweise Pyozintypisierung, Alginatbildung oder Kollagenase-aktivität charakterisiert. Wir untersuchten, inwiefern Agglutination und Proliferation der Bakterien sowie die Phagozytose speziell von P. aeruginosa durch SP-A und SP-D beeinflusst werden können. Die hier gezeigten Ergebnisse demonstrieren, dass SP-A und SP-D an P. aeruginosa binden. Die Interaktion mit den Bakterien ist kalziumabhängig, wird durch einfache Kohlehydrate gehemmt und somit über die Lektin/Kohlehydrat-Bindungsstellen der Surfactantproteine vermittelt. Trotz Bindung an plastikadhärente P. aeruginosa induziert SP-A keine Agglutination der Bakterien. SP-D hingegen agglutiniert P. aeruginosa. Darüber hinaus hemmt SP-D unabhängig von der Agglutination konzentrationsabhängig das Wachstum von P. aeruginosa. SP-D stimuliert die Phagozytose von Bakterien, indem es als Opsonin die Aufnahme der Keime durch eine humane Makrophagen Zelllinie verstärkt. SP-A beeinflusste die Phagozytose der untersuchten Keime dagegen nicht. Zusammenfassend konnte gezeigt werden, dass SP-A und SP-D unterschiedliche immunmodulatorische Funktionen haben. SP-D stimuliert durch verstärkte Phagozytose unabhängig vom LPS Serotyp die Abwehr Mukoviszidose-assoziierter Keime, speziell nicht mukoider P. aeruginosa. Beide Surfactantproteine binden spezifisch P. aeruginosa, aber nur SP-D induziert deren Agglutination und führt durch die Bildung von größeren Aggregaten möglicherweise zur Steigerung der pulmonalen Clearance der Bakterien.













